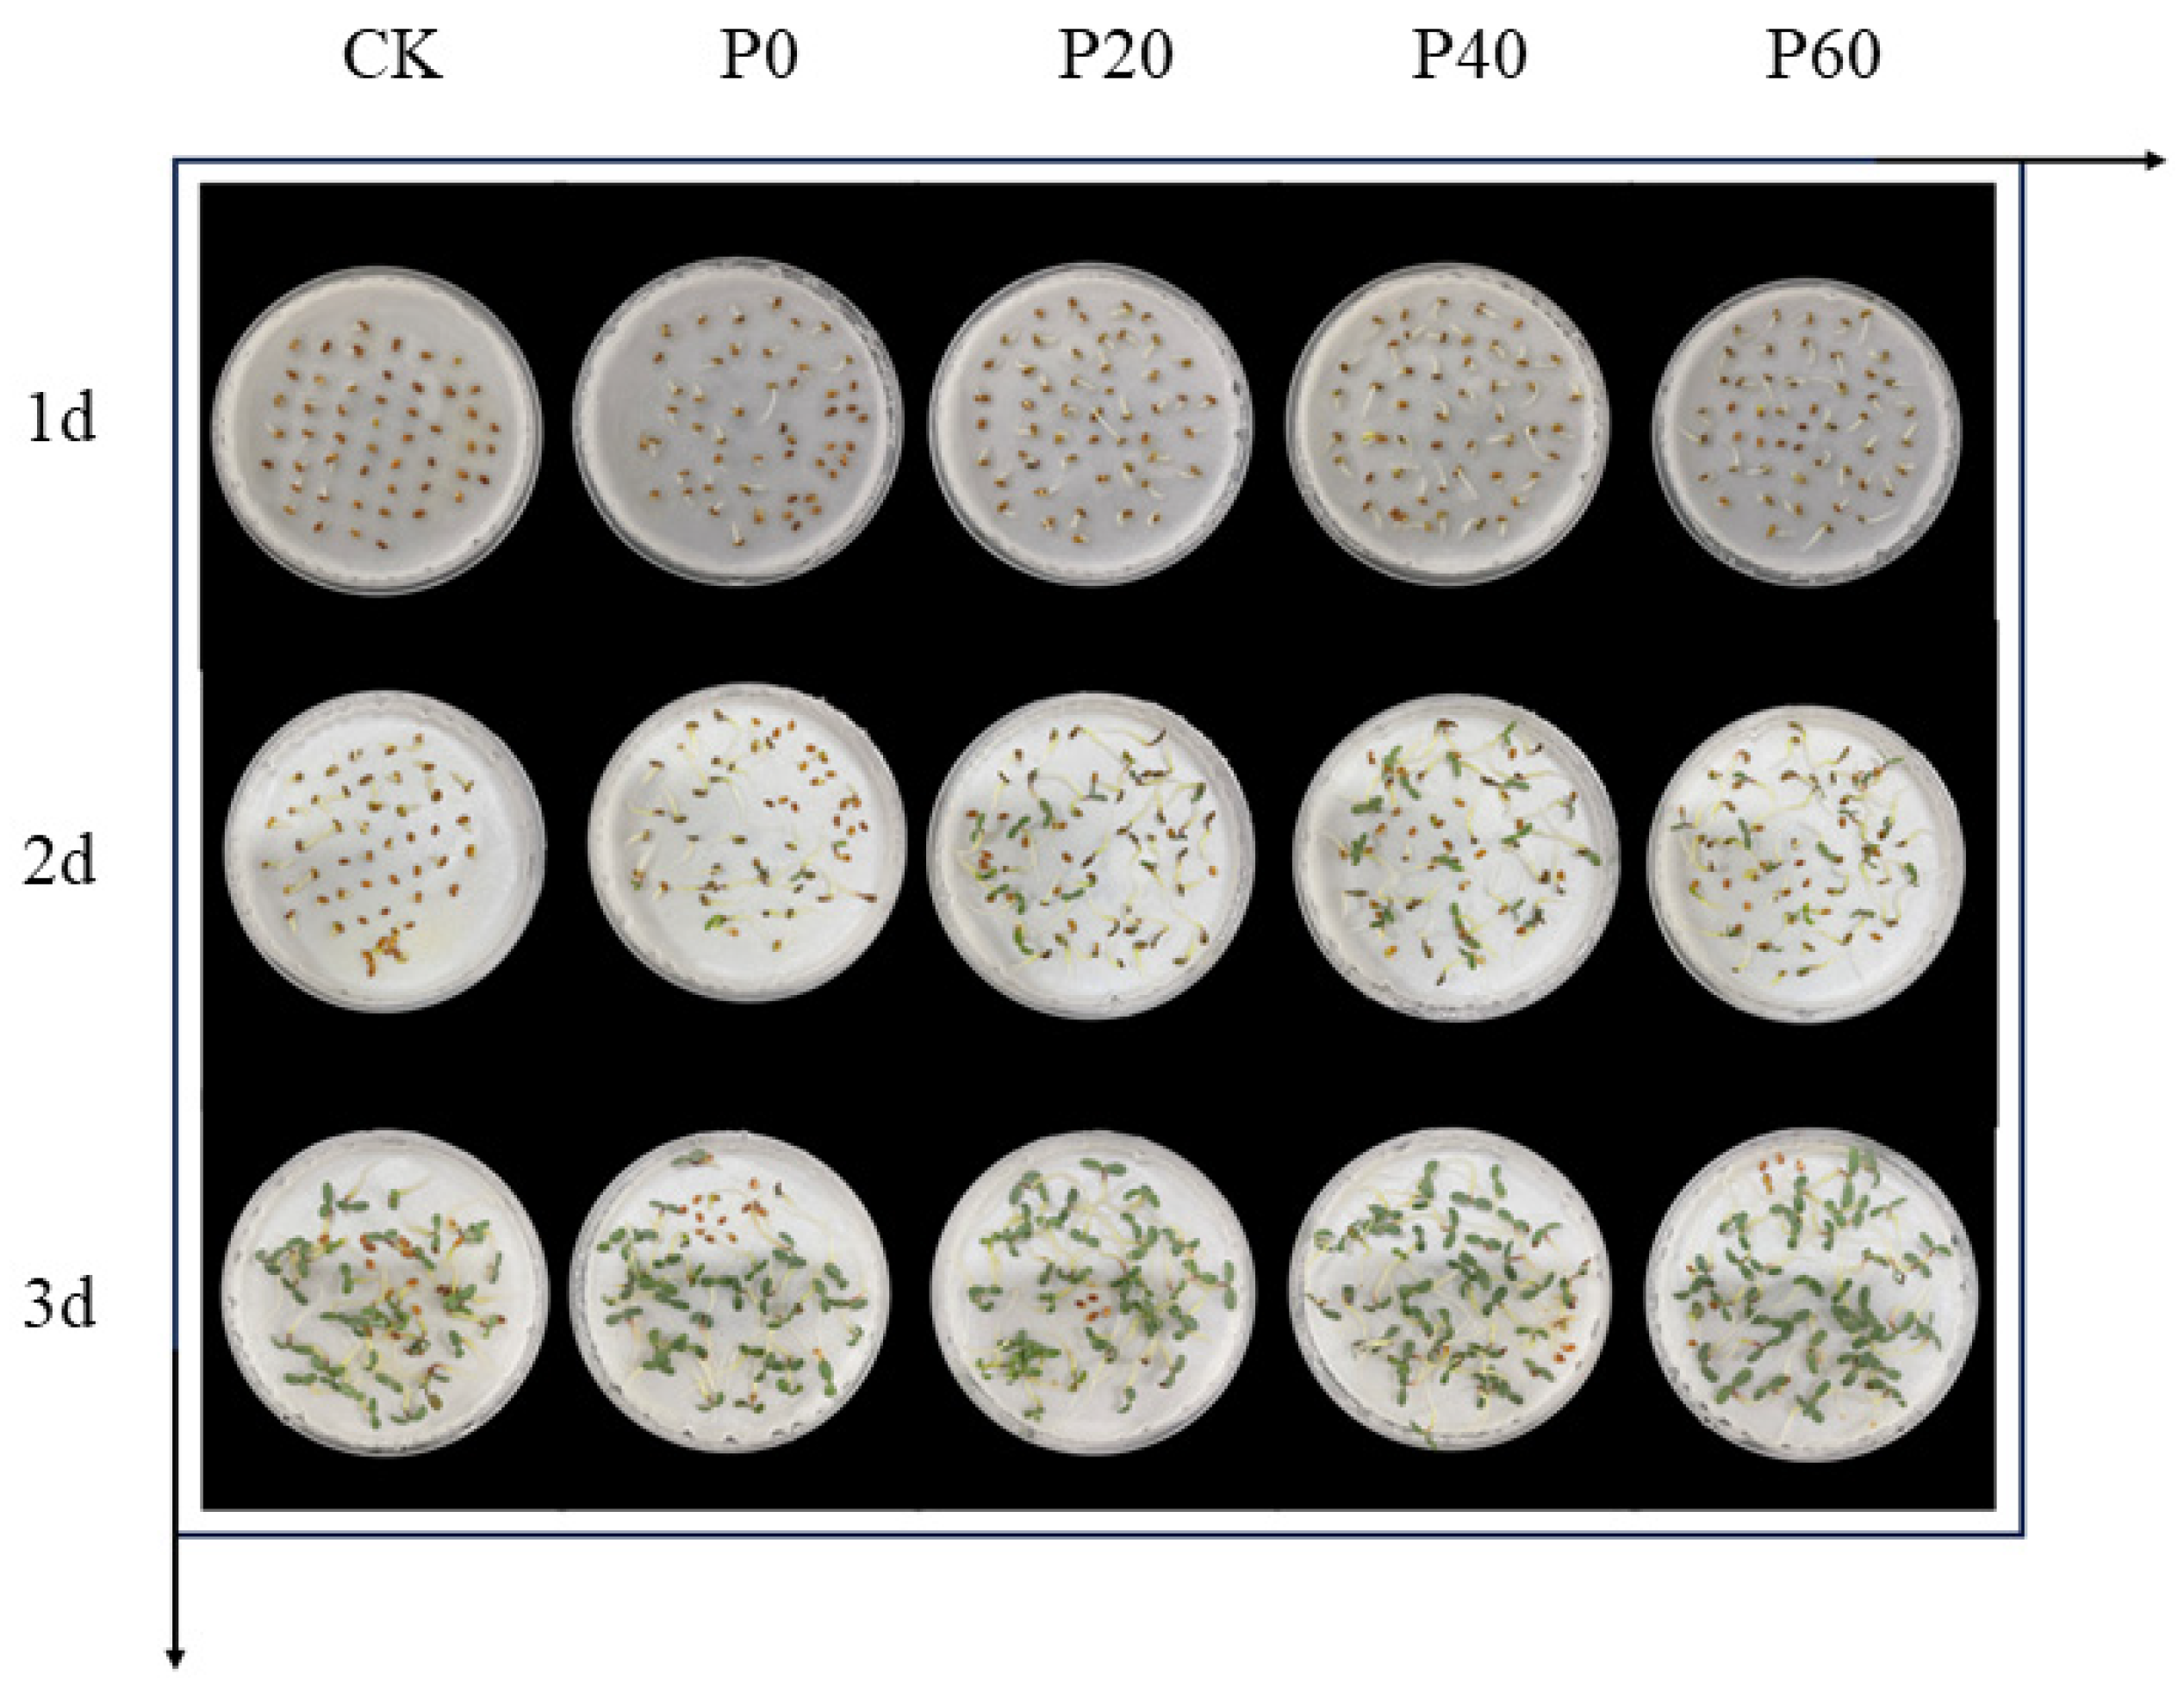
Plants 14 01236 g005

Effect of Green Synthesized Fe3O4NP Priming on Alfalfa Seed Germination Under Drought Stress
Abstract
1. Introduction
2. Results
2.1. Extraction of Flavonoids in G. biloba
2.2. Results of Nanomaterial Characterization
2.2.1. SEM, EDS, and DLS Characterization
2.2.2. FTIR Characterization
2.2.3. UV-Vis-NIR and XRD Characterization
2.3. Germination Parameters
2.3.1. Two-Factor ANOVA
2.3.2. Effect of Green Synthesized Fe3O4NPs on Alfalfa Seed Germination Under Drought Stress
2.3.3. Effects of Green Synthesized Fe3O4NPs on Alfalfa Seed Germination Parameters Under Drought Stress
2.4. Effect of Green Synthesized Fe3O4NP Priming on Alfalfa Seed α-Amylase Activity
2.5. Effect of Green Synthesized Fe3O4NP Priming on Root Surface Area of Alfalfa
3. Discussion
4. Materials and Methods
4.1. Materials
4.2. Preparation of the Green Synthesized Fe3O4 NPs
4.2.1. Preparation of G. biloba Extract
4.2.2. Determination of Total Flavonoids in G. biloba Extracts
4.2.3. Synthesis and Characterization of Nanomaterials
4.3. Seed Priming Experiment
4.3.1. Nanopriming
4.3.2. Seed Germination Test
4.4. Determination of α-Amylase Activity
4.5. Root Traits
4.6. Data Analysis
5. Conclusions
Author Contributions
Funding
Data Availability Statement
Conflicts of Interest
References
- Fernández-Pascual, E.; Mattana, E.; Pritchard, H.W. Seeds of Future Past: Climate Change and the Thermal Memory of Plant Reproductive Traits. Biol. Rev. 2019, 94, 439–456. [Google Scholar] [CrossRef] [PubMed]
- Hao, Y.; Yuan, X.; Zhang, M. Enhanced Relationship between Seasonal Soil Moisture Droughts and Vegetation under Climate Change over China. Agric. For. Meteorol. 2024, 358, 110258. [Google Scholar] [CrossRef]
- Shobanadevi, C.; Elangaimannan, R.; Vadivel, K. Screening of Blackgram Genotypes for Drought Tolerance using PEG (Polyethylene Glycol) Induced Drought Stress at Seedling Stage. Legum. Res.Int. J. 2021, 45, 968–973. [Google Scholar] [CrossRef]
- Liu, W.; Liu, L.; Gao, J.; Wu, S.; Liu, Y. Evaluation of the Effectiveness of Irrigation Methods and Fertilization Strategies for Alfalfa: A Meta-analysis. J. Agron. Crop. Sci. 2023, 209, 788–801. [Google Scholar] [CrossRef]
- Fan, W.; Tang, F.; Wang, J.; Dong, J.; Xing, J.; Shi, F. Drought-Induced Recruitment of Specific Root-Associated Bacteria Enhances Adaptation of Alfalfa to Drought Stress. Front. Microbiol. 2023, 14, 1114400. [Google Scholar] [CrossRef]
- Guo, M.; Zong, J.; Zhang, J.; Wei, L.; Wei, W.; Fan, R.; Zhang, T.; Tang, Z.; Zhang, G. Effects of Temperature and Drought Stress on the Seed Germination of a Peatland Lily (Lilium concolor Var. megalanthum). Front. Plant Sci. 2024, 15, 1462655. [Google Scholar] [CrossRef]
- Cappetta, E.; Regno, D.C.; Conte, M.; Castro-Hinojosa, C.; Sol-Fernández, D.S.; Vergata, C.; Buti, M.; Curcio, R.; Onder, A.; Mazzei, P.; et al. An Integrated Multilevel Approach Unveils Complex Seed–Nanoparticle Interactions and Their Implications for Seed Priming. ACS Nano 2023, 17, 22539–22552. [Google Scholar] [CrossRef]
- Rai-Kalal, P.; Tomar, R.S.; Jajoo, A. Seed Nanopriming by Silicon Oxide Improves Drought Stress Alleviation Potential in Wheat Plants. Funct. Plant Biol. 2021, 48, 905–915. [Google Scholar] [CrossRef]
- Song, K.; He, X. How to Improve Seed Germination with Green Nanopriming. Seed Sci. Technol. 2021, 49, 81–92. [Google Scholar] [CrossRef]
- Song, K.; Zhao, D.; Sun, H.; Gao, J.; Li, S.; Hu, T.; He, X. Green Nanopriming: Responses of Alfalfa (Medicago sativa L.) Seedlings to Alfalfa Extracts Capped and Light-Induced Silver Nanoparticles. BMC Plant Biol. 2022, 22, 323. [Google Scholar] [CrossRef]
- Guha, T.; Ravikumar, K.V.G.; Mukherjee, A.; Mukherjee, A.; Kundu, R. Nanopriming with Zero Valent Iron (nZVI) Enhances Germination and Growth in Aromatic Rice Cultivar (Oryza sativa Cv. Gobindabhog L.). Plant Physiol. Biochem. 2018, 127, 403–413. [Google Scholar] [CrossRef] [PubMed]
- Hu, C.; Wang, Y.; Deng, Y.; Yao, J.; Min, H.; Hu, J.; Fan, X.; Wang, S. Identification and Quantification of the Antioxidants in Leaf. Biomed. Chromatogr. 2024, 38, e5980. [Google Scholar] [CrossRef] [PubMed]
- Jain, R.; Mendiratta, S.; Kumar, L.; Srivastava, A. Green Synthesis of Iron Nanoparticles Using Artocarpus heterophyllus Peel Extract and Their Application as a Heterogeneous Fenton-like Catalyst for the Degradation of Fuchsin Basic Dye. Curr. Res. Green Sustain. Chem. 2021, 4, 100086. [Google Scholar] [CrossRef]
- Banić, N.D.; Abramović, B.F.; Krstić, J.B.; Šojić Merkulov, D.V.; Finčur, N.L.; Mitrić, M.N. Novel WO3/Fe3O4 Magnetic Photocatalysts: Preparation, Characterization and Thiacloprid Photodegradation. J. Ind. Eng. Chem. 2019, 70, 264–275. [Google Scholar] [CrossRef]
- Bharathi, D.; Preethi, S.; Abarna, K.; Nithyasri, M.; Kishore, P.; Deepika, K. Bio-Inspired Synthesis of Flower Shaped Iron Oxide Nanoparticles (FeONPs) Using Phytochemicals of Solanum lycopersicum Leaf Extract for Biomedical Applications. Biocatal. Agric. Biotechnol. 2020, 27, 101698. [Google Scholar] [CrossRef]
- Katata-Seru, L.; Moremedi, T.; Aremu, O.S.; Bahadur, I. Green Synthesis of Iron Nanoparticles Using Moringa oleifera Extracts and Their Applications: Removal of Nitrate from Water and Antibacterial Activity against Escherichia coli. J. Mol. Liq. 2018, 256, 296–304. [Google Scholar] [CrossRef]
- Bassim, S.; Mageed, A.K.; AbdulRazak, A.A.; Majdi, H.S. Green Synthesis of Fe3O4 Nanoparticles and Its Applications in Wastewater Treatment. Inorganics 2022, 10, 260. [Google Scholar] [CrossRef]
- Yusefi, M.; Shameli, K.; Yee, S.O.; Teow, S.-Y.; Hedayatnasab, Z.; Jahangirian, H.; Webster, T.J.; Kuča, K. Green Synthesis of Fe3O4 Nanoparticles Stabilized by a Garcinia mangostana Fruit Peel Extract for Hyperthermia and Anticancer Activities. Int. J. Nanomed. 2021, 16, 2515–2532. [Google Scholar] [CrossRef]
- Win, T.T.; Khan, S.; Bo, B.; Zada, S.; Fu, P. Green Synthesis and Characterization of Fe3O4 Nanoparticles Using Chlorella-K01 Extract for Potential Enhancement of Plant Growth Stimulating and Antifungal Activity. Sci. Rep. 2021, 11, 21996. [Google Scholar] [CrossRef]
- Sun, X.; Fu, M.; Lou, S.; Li, D.; Han, X.; Gao, S.; Xiu, J.; Wang, J.; Ren, Y. Optimization of Flavonoids Extracted from Hawthorn (Crataegus pinnatifida) by Ultrasonic-Assisted Deep Eutectic Solvent. Food Biosci. 2024, 59, 103767. [Google Scholar] [CrossRef]
- Biernacka, P.; Adamska, I.; Felisiak, K. The Potential of Ginkgo biloba as a Source of Biologically Active Compounds—A Review of the Recent Literature and Patents. Molecules 2023, 28, 3993. [Google Scholar] [CrossRef] [PubMed]
- Yang, W.; Huang, G. Extraction Methods and Activities of Natural Glucans. Trends Food Sci. Technol. 2021, 112, 50–57. [Google Scholar] [CrossRef]
- Cheng, J.; Xu, C.; Sun, Y.; Yu, Q.; Ding, S.; Wang, Y.; Wei, W.; Xu, W.; Zhang, C.; Gong, D. Ultrasonic-Assisted Extraction of Total Flavonoids from Zanthoxylum bungeanum Residue and Their Allelopathic Mechanism on Microcystis aeruginosa. Sci. Rep. 2024, 14, 13192. [Google Scholar] [CrossRef] [PubMed]
- Sangut, I.J.; Samec, D. Seasonal Variation of Polyphenols and Pigments in Ginkgo (Ginkgo biloba L.) Leaves: Focus on 3′,8″-Biflavones. Plants 2024, 13, 3044. [Google Scholar] [CrossRef]
- Ifthikar, J.; Shahib, I.I.; Jiang, W.; Senthilnithy, R.; Elkhlifi, Z.; Wang, J.; Chen, Z. Review on Technologies for the Development of Effective and Practical Chromate Removal from Wastewaters. J. Environ. Chem. Eng. 2023, 11, 110735. [Google Scholar] [CrossRef]
- Samrot, A.V.; SaiPriya, C.; Selvarani, A.J.; Subbu, R.V.; Cypriyana, P.J.J.; Lavanya, Y.; Afreen, R.S.; Sangeetha, P.; Priyanka, R.B.S.; Soundarya, P.; et al. A Study on Influence of Superparamagnetic Iron Oxide Nanoparticles (SPIONs) on Green Gram (Vigna radiata L.) and Earthworm (Eudrilus eugeniae L.). Mater. Res. Express 2020, 7, 55002. [Google Scholar] [CrossRef]
- Singh, K.; Yadav, S. Biosynthesis of a Range of ZnO Nanoparticles Utilising Salvia hispanica L. Seed Extract and Evaluation of Their Bioactivity. Sci. Rep. 2025, 15, 4043. [Google Scholar] [CrossRef]
- Wehbe, N.; Mesmar, J.E.; Kurdi, R.E.; Al-Sawalmih, A.; Badran, A.; Patra, D.; Baydoun, E. Halodule Uninervis Extract Facilitates the Green Synthesis of Gold Nanoparticles with Anticancer Activity. Sci. Rep. 2025, 15, 4286. [Google Scholar] [CrossRef]
- Madhavi, V.; Prasad, T.N.V.K.V.; Reddy, A.V.B.; Reddy, B.R.; Madhavi, G. Application of Phytogenic Zerovalent Iron Nanoparticles in the Adsorption of Hexavalent Chromium. Spectrochim. Acta Part A 2013, 116, 17–25. [Google Scholar] [CrossRef]
- Benković, M.; Valinger, D.; Jurina, T.; Kljusurić, J.G.; Tušek, A.J. Biocatalysis as a Green Approach for Synthesis of Iron Nanoparticles—Batch and Microflow Process Comparison. Catalysts 2023, 13, 112. [Google Scholar] [CrossRef]
- Batool, F.; Iqbal, M.S.; Khan, S.-U.-D.; Khan, J.; Ahmed, B.; Qadir, M.I. Biologically Synthesized Iron Nanoparticles (FeNPs) from Phoenix Dactylifera Have Anti-Bacterial Activities. Sci. Rep. 2021, 11, 22132. [Google Scholar] [CrossRef] [PubMed]
- Xu, N.; Sui, X.; Chen, Z.; Niu, J.; Guo, Z.; Wang, Q. Seed Soaking with Salicylic Acid Improves Alfalfa (Medicago sativa L.) Germination by Involving the Antioxidation System. Acta Physiol. Plant. 2023, 45, 128. [Google Scholar] [CrossRef]
- Mouradi, M.; Bouizgaren, A.; Farissi, M.; Makoudi, B.; Kabbadj, A.; Very, A.-A.; Sentenac, H.; Qaddoury, A.; Ghoulam, C. Osmopriming Improves Seeds Germination, Growth, Antioxidant Responses and Membrane Stability during Early Stage of Moroccan Alfalfa Populations under Water Deficit. Chil. J. Agric. Res. 2016, 76, 265–272. [Google Scholar] [CrossRef][Green Version]
- Siddiqui, S.A.; Blinov, A.V.; Serov, A.V.; Gvozdenko, A.A.; Kravtsov, A.A.; Nagdalian, A.A.; Raffa, V.V.; Maglakelidze, D.G.; Blinova, A.A.; Kobina, A.V.; et al. Effect of Selenium Nanoparticles on Germination of Hordéum Vulgáre Barley Seeds. Coatings 2021, 11, 862. [Google Scholar] [CrossRef]
- Alkhatib, R.; Alkhatib, B.; Abdo, N. Effect of Fe3O4 Nanoparticles on Seed Germination in Tobacco. Environ. Sci. Pollut. Res. 2021, 28, 53568–53577. [Google Scholar] [CrossRef]
- Ndou, N.; Rakgotho, T.; Nkuna, M.; Doumbia, I.Z.; Mulaudzi, T.; Ajayi, R.F. Green Synthesis of Iron Oxide (Hematite) Nanoparticles and Their Influence on Sorghum bicolor Growth under Drought Stress. Plants 2023, 12, 1425. [Google Scholar] [CrossRef]
- Sreelakshmi, B.; Induja, S.; Adarsh, P.P.; Rahul, H.L.; Arya, S.M.; Aswana, S.; Haripriya, R.; Aswathy, B.R.; Manoj, P.K.; Vishnudasan, D. Drought Stress Amelioration in Plants Using Green Synthesised Iron Oxide Nanoparticles. Mater. Today Proc. 2021, 41, 723–727. [Google Scholar] [CrossRef]
- Dong, J.; Jiang, Y.; Lyu, M.; Cao, C.; Li, X.; Xiong, X.; Lin, W.; Yang, Z.; Chen, G.; Yang, Y.; et al. Drought Changes the Trade-off Strategy of Root and Arbuscular Mycorrhizal Fungi Growth in a Subtropical Chinese Fir Plantation. Forests 2023, 14, 114. [Google Scholar] [CrossRef]
- Baozhu, L.; Ruonan, F.; Yanting, F.; Runan, L.; Hui, Z.; Tingting, C.; Jiong, L.; Han, L.; Xiang, Z.; Chun-peng, S. The Flavonoid Biosynthesis Regulator PFG3 Confers Drought Stress Tolerance in Plants by Promoting Flavonoid Accumulation. Environ. Exp. Bot. 2022, 196, 104792. [Google Scholar] [CrossRef]
- Malekzadeh, E.; Tatari, A.; Motlagh, M.B.; Nohesara, M.; Mohammadi, S. A Novel Approach for the Green Synthesis of Iron Nanoparticles Using Marigold Extract, Black Liquor, and Nanocellulose: Effect on Marigold Growth Parameters. Int. J. Biol. Macromol. 2024, 267, 131552. [Google Scholar] [CrossRef]
- Herrera-Pool, E.; Ramos-Díaz, A.L.; Lizardi-Jiménez, M.A.; Pech-Cohuo, S.; Ayora-Talavera, T.; Cuevas-Bernardino, J.C.; García-Cruz, U.; Pacheco, N. Effect of Solvent Polarity on the Ultrasound Assisted Extraction and Antioxidant Activity of Phenolic Compounds from Habanero Pepper Leaves (Capsicum chinense) and Its Identification by UPLC-PDA-ESI-MS/MS. Ultrason. Sonochem. 2021, 76, 105658. [Google Scholar] [CrossRef] [PubMed]
- Prasad, C.; Gangadhara, S.; Venkateswarlu, P. Bio-Inspired Green Synthesis of Fe3O4 Magnetic Nanoparticles Using Watermelon Rinds and Their Catalytic Activity. Appl. Nanosci. 2016, 6, 797–802. [Google Scholar] [CrossRef]
- Yang, W.; Liu, S.; Yuan, G.; Liu, P.; Qi, D.; Dong, X.; Liu, H.; Liu, G.; Li, X. Germination Characteristics among Different Sheepgrass (Leymus chinensis) Germplasm during the Seed Development and after-Ripening Stages. PeerJ 2019, 7, e6688. [Google Scholar] [CrossRef] [PubMed]
- Pariona, N.; Martínez, A.I.; Hernandez-Flores, H.; Clark-Tapia, R. Effect of Magnetite Nanoparticles on the Germination and Early Growth of Quercus macdougallii. Sci. Total Environ. 2017, 575, 869–875. [Google Scholar] [CrossRef]
- Neto, F.J.D.; Carneiro, D.C.d.S.; Putti, F.F.; Rodrigues, J.D.; Tecchio, M.A.; Leonel, S.; Silva, M.d.S. Physiological Indexes in Seed Germination and Seedling Growth of Rangpur Lime (Citrus limonia L. Osbeck) under Plant Growth Regulators. Agronomy 2024, 14, 2066. [Google Scholar] [CrossRef]
- Ramana, S.; Biswas, A.K.; Kundu, S.; Saha, J.K.; Yadava, R.B.R. Effect of Distillery Effluent on Seed Germination in Some Vegetable Crops. Bioresour. Technol. 2002, 82, 273–275. [Google Scholar] [CrossRef]
- Yar, A.; Ullah, R.; Khan, M.N.; Iqbal, M.; Ercisli, S.; Kaplan, A.; Olana, D.D.; Javed, M.A.; Mohamed, E.I.; Baowidan, S.; et al. Unveiling the Germination Patterns of Alternaria porri (Ellis) by Using Regression Analysis and Hydrothermal Time Modeling. Sci. Rep. 2024, 14, 25694. [Google Scholar] [CrossRef]

| Number | Wavenumber (cm−1) | Absorbance (Abs) | Absorption Band Strength | Band Assignments |
|---|---|---|---|---|
| 1 | 596 | 0.121212 | Weak | Fe-O Stretching |
| 2 | 714 | 0.103149 | Weak | C-H Stretching |
| 3 | 820 | 0.096330 | Weak | C-H Stretching |
| 4 | 1056 | 0.402104 | Medium | C-O Stretching |
| 5 | 1261 | 0.334503 | Medium | C-O Stretching |
| 6 | 1373 | 0.412196 | Medium | C-H Stretching |
| 7 | 1450 | 0.430146 | Medium | C-H Stretching |
| 8 | 1537 | 0.453304 | Medium | C=C or N-H Stretching |
| 9 | 1622 | 0.614133 | Strong | C=C Stretching |
| 10 | 1701 | 0.232626 | Medium | C=O Stretching |
| 11 | 2846 | 0.440695 | Medium | C-H Stretching |
| 12 | 2930 | 0.617398 | Strong | C-H Stretching |
| 13 | 3369 | 0.498590 | Medium | O-H Stretching |
| Source | SS | df | Mean Square | F | P |
|---|---|---|---|---|---|
| Germination rate (GR) | |||||
| Drought stress concentration (D) | 11,159.64 | 2 | 5579.82 | 389.89 | 3.39 × 10−22 |
| Priming concentration (P) | 5501.87 | 4 | 1375.47 | 96.11 | 1.17 × 10−16 |
| D*P | 2346.13 | 8 | 293.27 | 20.49 | 3.55 × 10−10 |
| Germination potential (GP) | |||||
| Drought stress concentration (D) | 8659.38 | 2 | 4329.69 | 369.01 | 7.52 × 10−22 |
| Priming concentration (P) | 7591.64 | 4 | 1897.91 | 161.75 | 7.65 × 10−20 |
| D*P | 2049.96 | 8 | 256.24 | 21.84 | 1.62 × 10−10 |
| Germination index (GI) | |||||
| Drought stress concentration (D) | 21,618.61 | 2 | 10809.31 | 745.43 | 2.66 × 10−26 |
| Priming concentration (P) | 11,065.53 | 4 | 2766.38 | 190.78 | 7.17 × 10−21 |
| D*P | 2614.37 | 8 | 326.8 | 22.54 | 1.09 × 10−10 |
| Vigor index (VI) | |||||
| Drought stress concentration (D) | 5330.48 | 2 | 2665.24 | 9.68 | 5.70 × 10−4 |
| Priming concentration (P) | 371,681.36 | 4 | 92920.34 | 337.5 | 1.79 × 10−24 |
| D*P | 80,256.32 | 8 | 10032.04 | 36.44 | 2.20 × 10−13 |
| Mean germination time (MGT) | |||||
| Drought stress concentration (D) | 6.29 | 2 | 1.57 | 32.63 | 1.56 × 10−10 |
| Priming concentration (P) | 2.79 | 4 | 1.40 | 28.95 | 9.94 × 10−8 |
| D*P | 2.99 | 8 | 0.37 | 7.75 | 1.36 × 10−5 |
| Germination peak value (GPV) | |||||
| Drought stress concentration (D) | 50.80 | 2 | 12.7 | 5.21 | 2.63 × 10−3 |
| Priming concentration (P) | 79.62 | 4 | 39.8 | 16.32 | 1.60 × 10−5 |
| D*P | 46.62 | 8 | 5.83 | 2.39 | 4.01 × 10−2 |
| Final germination percentage (FGP) | |||||
| Drought stress concentration (D) | 0.55 | 2 | 0.14 | 96.11 | 1.17 × 10−16 |
| Priming concentration (P) | 1.12 | 4 | 0.56 | 389.90 | 3.40 × 10−22 |
| D*P | 0.24 | 8 | 0.03 | 20.50 | 3.54 × 10−10 |
| Germination speed index (GSI) | |||||
| Drought stress concentration (D) | 0.15 | 2 | 0.04 | 183.48 | 1.26 × 10−20 |
| Priming concentration (P) | 0.36 | 4 | 0.18 | 892.68 | 1.87 × 10−27 |
| D*P | 0.04 | 8 | 0.01 | 25.34 | 2.51 × 10−11 |
| Treatment | GR (%) | GP | VI | GI | MGT (d) | GPV | FGP | GSI |
|---|---|---|---|---|---|---|---|---|
| CK-D0 | 83.33 ± 8.33 b | 60.00 ± 2.00 c | 48.94 ± 3.48 c | 210.02 ± 17.77 d | 3.37 ± 0.16 a | 5.95 ± 0.59 b | 0.83 ± 0.08 b | 0.17 ± 0.01 c |
| P0-D0 | 90.67 ± 1.15 ab | 87.33 ± 6.43 b | 98.69 ± 6.47 ab | 250.26 ± 8.79 c | 1.55 ± 0.30 b | 10.98 ± 4.31 a | 0.91 ± 0.01 ab | 0.37 ± 0.02 b |
| P20-D0 | 99.33 ± 1.15 a | 95.33 ± 1.15 a | 105.51 ± 3.88 ab | 365.91 ± 16.91 a | 1.62 ± 0.14 b | 8.43 ± 1.33 ab | 0.99 ± 0.01 a | 0.39 ± 0.02 ab |
| P40-D0 | 97.33 ± 3.06 a | 90.67 ± 1.15 ab | 107.44 ± 2.80 a | 321.43 ± 16.06 b | 1.60 ± 0.22 b | 7.85 ± 1.35 ab | 0.97 ± 0.03 a | 0.41 ± 0.01 a |
| P60-D0 | 96.00 ± 5.29 a | 88.00 ± 5.29 ab | 96.38 ± 7.24 b | 271.41 ± 18.63 c | 1.91 ± 0.33 b | 7.25 ± 0.98 ab | 0.96 ± 0.05 a | 0.36 ± 0.03 b |
| CK-D10 | 50.00 ± 0.00 c | 46.00 ± 2.00 d | 32.84 ± 0.63 d | 151.63 ± 16.75 d | 2.71 ± 0.06 a | 4.17 ± 0.00 b | 0.50 ± 0.00 c | 0.10 ± 0.00 d |
| P0-D10 | 75.33 ± 1.15 b | 70.00 ± 2.00 c | 56.48 ± 1.94 c | 265.04 ± 6.47 c | 2.38 ± 0.15 b | 6.81 ± 1.20 a | 0.75 ± 0.01 b | 0.19 ± 0.01 c |
| P20-D10 | 86.00 ± 2.00 a | 84.00 ± 2.00 a | 79.00 ± 2.83 a | 362.05 ± 30.91 a | 1.84 ± 0.06 c | 7.66 ± 0.99 a | 0.86 ± 0.02 a | 0.27 ± 0.01 a |
| P40-D10 | 80.00 ± 4.00 ab | 74.00 ± 5.29 bc | 65.53 ± 5.37 b | 370.09 ± 18.28 a | 2.16 ± 0.21 b | 6.83 ± 1.49 a | 0.80 ± 0.04 ab | 0.22 ± 0.02 b |
| P60-D10 | 86.67 ± 7.57 a | 80.67 ± 6.11 ab | 69.36 ± 3.30 b | 313.85 ± 14.49 b | 2.19 ± 0.13 b | 7.42 ± 1.82 a | 0.87 ± 0.08 a | 0.23 ± 0.01 b |
| CK-D15 | 39.33 ± 1.15 d | 33.33 ± 1.15 d | 23.95 ± 1.02 c | 45.71 ± 7.77 e | 2.96 ± 0.23 a | 3.12 ± 0.24 b | 0.39 ± 0.01 d | 0.08 ± 0.00 c |
| P0-D15 | 30.67 ± 1.15 e | 27.33 ± 3.06 e | 19.03 ± 1.83 d | 153.58 ± 15.27 d | 2.84 ± 0.47 ab | 2.97 ± 0.68 b | 0.31 ± 0.01 e | 0.06 ± 0.00 c |
| P20-D15 | 68.00 ± 2.00 b | 63.33 ± 1.15 b | 50.17 ± 4.19 a | 382.39 ± 13.65 b | 2.38 ± 0.18 b | 6.06 ± 0.82 a | 0.68 ± 0.02 b | 0.16 ± 0.02 a |
| P40-D15 | 78.00 ± 2.00 a | 73.33 ± 2.31 a | 54.63 ± 2.78 a | 426.81 ± 14.31 a | 2.50 ± 0.12 ab | 6.33 ± 1.45 a | 0.78 ± 0.02 a | 0.17 ± 0.01 a |
| P60-D15 | 58.00 ± 4.00 c | 55.33 ± 2.31 c | 41.73 ± 2.58 b | 323.28 ± 18.40 c | 2.40 ± 0.17 b | 5.70 ± 1.37 a | 0.58 ± 0.04 c | 0.13 ± 0.01 b |
| Control | P0 | P20 | P40 | P60 | |
|---|---|---|---|---|---|
| D0 | 0.74 ± 0.03 a | 0.71 ± 0.13 a | 0.77 ± 0.11 a | 0.68 ± 0.11 a | 0.80 ± 0.12 a |
| D10 | 0.58 ± 0.07 b | 0.68 ± 0.14 a | 0.73 ± 0.08 a | 0.68 ± 0.08 a | 0.74 ± 0.09 a |
| D15 | 0.52 ± 0.07 a | 0.53 ± 0.10 ab | 0.67 ± 0.12 b | 0.76 ± 0.10 c | 0.80 ± 0.06 c |
| Drought Stress Concentration | Priming Concentration | Code |
|---|---|---|
| 0% PEG-6000 | Unprimed | CK-0 |
| 0 mg/L | P0-0 | |
| 20 mg/L | P20-0 | |
| 40 mg/L | P40-0 | |
| 60 mg/L | P60-0 | |
| 10% PEG-6000 | Unprimed | CK-10 |
| 0 mg/L | P0-10 | |
| 20 mg/L | P20-10 | |
| 40 mg/L | P40-10 | |
| 60 mg/L | P60-10 | |
| 15% PEG-6000 | Unprimed | CK-15 |
| 0 mg/L | P0-15 | |
| 20 mg/L | P20-15 | |
| 40 mg/L | P40-15 | |
| 60 mg/L | P60-15 |
Disclaimer/Publisher’s Note: The statements, opinions and data contained in all publications are solely those of the individual author(s) and contributor(s) and not of MDPI and/or the editor(s). MDPI and/or the editor(s) disclaim responsibility for any injury to people or property resulting from any ideas, methods, instructions or products referred to in the content. |
© 2025 by the authors. Licensee MDPI, Basel, Switzerland. This article is an open access article distributed under the terms and conditions of the Creative Commons Attribution (CC BY) license (https://creativecommons.org/licenses/by/4.0/).
Share and Cite
Wang, X.; Ge, M.; He, X. Effect of Green Synthesized Fe3O4NP Priming on Alfalfa Seed Germination Under Drought Stress. Plants 2025, 14, 1236. https://doi.org/10.3390/plants14081236
Wang X, Ge M, He X. Effect of Green Synthesized Fe3O4NP Priming on Alfalfa Seed Germination Under Drought Stress. Plants. 2025; 14(8):1236. https://doi.org/10.3390/plants14081236
Chicago/Turabian StyleWang, Xinyue, Mengting Ge, and Xueqing He. 2025. "Effect of Green Synthesized Fe3O4NP Priming on Alfalfa Seed Germination Under Drought Stress" Plants 14, no. 8: 1236. https://doi.org/10.3390/plants14081236
APA StyleWang, X., Ge, M., & He, X. (2025). Effect of Green Synthesized Fe3O4NP Priming on Alfalfa Seed Germination Under Drought Stress. Plants, 14(8), 1236. https://doi.org/10.3390/plants14081236
